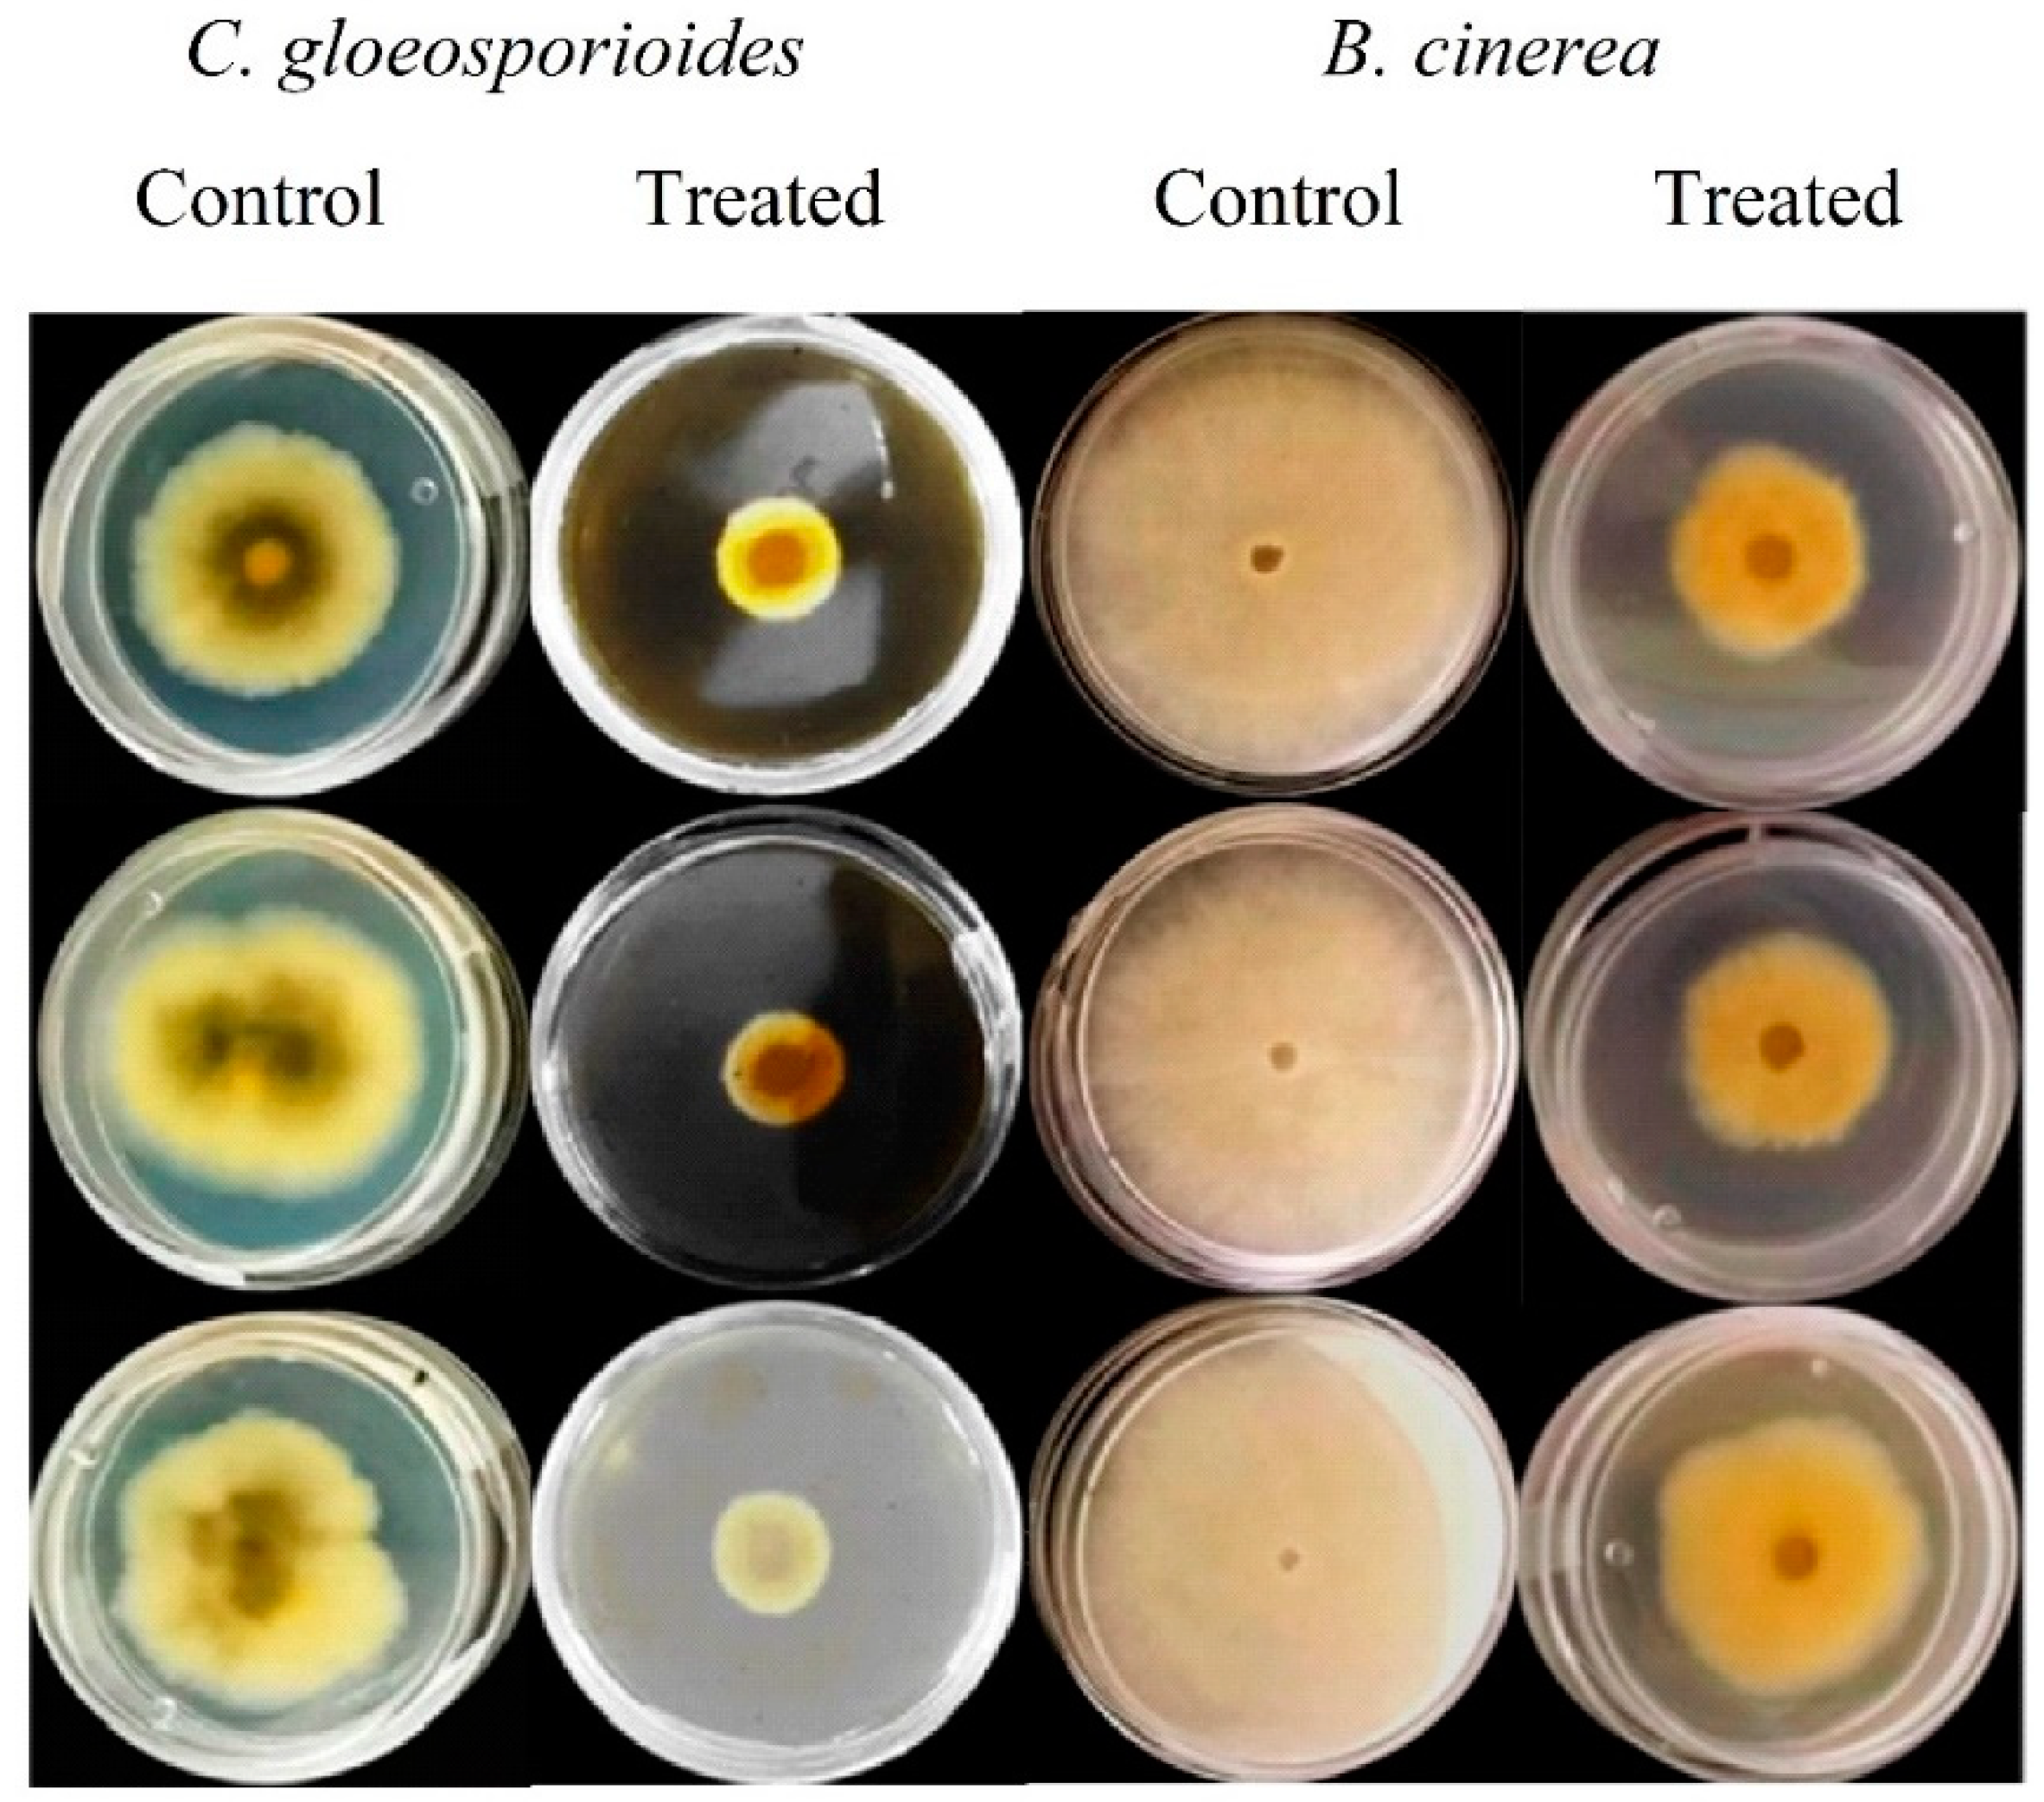
Plants 12 00217 g001 Plants 12 00217 g001

Evaluation of Pretreatments and Extraction Conditions on the Antifungal and Antioxidant Effects of Garlic (Allium sativum) Peel Extracts
Abstract
1. Introduction
2. Materials and Methods
2.1. Garlic Peels
2.2. Reagents and Solvents
2.3. Microorganisms
2.4. Selection of Garlic Pretreatments
2.5. Antifungal Activity
Disease Incidence
2.6. Total Phenolic Compounds
2.7. Total Flavonoids
2.8. Antioxidant Capacity
2.9. Statistical Analysis
3. Results and Discussion
3.1. Pretreatment Effect on Antifungal and Antioxidant Capacity of Garlic Peel Extracts
3.2. Evaluation of Extraction Conditions on In Vitro and In Vivo Antifungal Activities of Garlic Peel Extracts
4. Conclusions
Author Contributions
Funding
Institutional Review Board Statement
Informed Consent Statement
Data Availability Statement
Acknowledgments
Conflicts of Interest
References
- Da Silva, R.F.; Carneiro, C.N.; de Sousa, C.B.d.C.; Gomez, F.J.V.; Espino, M.; Boiteux, J.; Fernández, M.d.; Silva, M.F.; Dias, F.d. Sustainable Extraction Bioactive Compounds Procedures in Medicinal Plants Based on the Principles of Green Analytical Chemistry: A Review. Microchem. J. 2022, 175, 107184. [Google Scholar] [CrossRef]
- Alexandru Vlaicu, P.; Elena Untea, A.; Paula Turcu, R.; Saracila, M.; Dumitra Panaite, T.; Maria Cornescu, G. Nutritional Composition and Bioactive Compounds of Basil, Thyme and Sage Plant Additives and Their Functionality on Broiler Thigh Meat Quality. Foods 2022, 11, 1105. [Google Scholar] [CrossRef] [PubMed]
- Jattar-Santiago, K.Y.; Ramírez-López, C.; Hernández-Carranza, P.; Avila-Sosa, R.; Ruiz-López, I.I.; Ochoa-Velasco, C.E. Effect of Extraction Conditions on the Antioxidant Compounds from Habanero Pepper (Capsicum chinense) and Its Potential Use as Antimicrobial. J. Food Process. Preserv. 2022, 46, e16427. [Google Scholar] [CrossRef]
- Essien, S.O.; Young, B.; Baroutian, S. Recent Advances in Subcritical Water and Supercritical Carbon Dioxide Extraction of Bioactive Compounds from Plant Materials. Trends Food Sci. Technol. 2020, 97, 156–169. [Google Scholar] [CrossRef]
- Dos Santos, P.C.M.; da Silva, L.M.R.; Magalhaes, F.E.A.; Cunha, F.E.T.; Ferreira, M.J.G.; de Figueiredo, E.A.T. Garlic (Allium sativum L.) Peel Extracts: From Industrial by-Product to Food Additive. Appl. Food Res. 2022, 2, 100186. [Google Scholar] [CrossRef]
- Ezeorba, T.P.C.; Chukwudozie, K.I.; Ezema, C.A.; Anaduaka, E.G.; Nweze, E.J.; Okeke, E.S. Potentials for Health and Therapeutic Benefits of Garlic Essential Oils: Recent Findings and Future Prospects. Pharmacol. Res.-Mod. Chin. Med. 2022, 3, 100075. [Google Scholar] [CrossRef]
- Chaudhary, B.U.; Lingayat, S.; Banerjee, A.N.; Kale, R.D. Development of Multifunctional Food Packaging Films Based on Waste Garlic Peel Extract and Chitosan. Int. J. Biol. Macromol. 2021, 192, 479–490. [Google Scholar] [CrossRef]
- Al-Defiery, M.E.; Al-Muttairi, A.K.; Saeed, H.H.; Hadi, R.K. Antimicrobial Activity of Garlic and Pomegranate Peel Extracts against Some Pathogenic Bacteria. IOP Conf. Ser. Earth Environ. Sci. 2021, 722, 012017. [Google Scholar] [CrossRef]
- Singiri, J.R.; Swetha, B.; Ben-Natan, A.; Grafi, G. What Worth the Garlic Peel. Int. J. Mol. Sci. 2022, 23, 2126. [Google Scholar] [CrossRef]
- Naqvi, S.A.Z.; Irfan, A.; Zahoor, A.F.; Zafar, M.; Maria, A.; Chand, A.J.; Ashfaq, S. Determination of Antimicrobial and Antioxidant Potential of Agro-Waste Peels. An. Acad. Bras. Cienc. 2020, 92, 1–12. [Google Scholar] [CrossRef]
- Pardede, C.; Iriany; Tambun, R.; Fitri, M.D.; Husna, R. Extraction of Tannin from Garlic Skins by Using Microwave with Ethanol as Solvent. IOP Conf. Ser. Mater. Sci. Eng. 2020, 801, 012054. [Google Scholar] [CrossRef]
- Uçak, I. Physicochemical and Antimicrobial Effects of Gelatin-Based Edible Films Incorporated with Garlic Peel Extract on the Rainbow Trout Fillets. Prog. Nutr. 2019, 21, 232–240. [Google Scholar] [CrossRef]
- Chaudhary, B.; Lingayat, S.; Banarjee, A.; Kale, R. Preparation and Characterization of Antioxidant, Antimicrobial, and UV-Light Protection Film Based on Poly(Vinyl Alcohol) and Garlic Peel Extract. Waste Biomass Valorization 2022, 13, 4717–4734. [Google Scholar] [CrossRef]
- Salim, M.H.; Kassab, Z.; Abdellaoui, Y.; García-Cruz, A.; Soumare, A.; Ablouh, E.H.; El Achaby, M. Exploration of Multifunctional Properties of Garlic Skin Derived Cellulose Nanocrystals and Extracts Incorporated Chitosan Biocomposite Films for Active Packaging Application. Int. J. Biol. Macromol. 2022, 210, 639–653. [Google Scholar] [CrossRef]
- Kim, R.J.; Kang, M.J.; Lee, S.J.; Shin, J.H.; Sung, N.J. Physicochemical Characteristics and Antioxidant Activities of Fermented Garlic Husk. J. Korean Soc. Food Sci. Nutr. 2010, 39, 1731–1738. [Google Scholar] [CrossRef]
- Min, J.H.; Jeong, J.H.; Park, Y.U.; Lee, J.S.; Lee, S.J.; Chang, W.B. Quality Characteristics of Garlic Peel According to Processing Methods. Korean J. Food Preserv. 2020, 27, 32–37. [Google Scholar] [CrossRef]
- Aguilar-Sánchez, R.; Munguía-Pérez, R.; Reyes-Jurado, F.; Navarro-Cruz, A.R.; Cid-Pérez, T.S.; Hernández-Carranza, P.; Beristain-Bauza, S.C.; Ochoa-Velasco, C.E.; Avila-Sosa, R. Structural, Physical, and Antifungal Characterization of Starch Edible Films Added with Nanocomposites and Mexican Oregano (Lippia berlandieri Schauer) Essential Oil. Molecules 2019, 24, 2340. [Google Scholar] [CrossRef]
- Hesami, G.; Darvishi, S.; Zarei, M.; Hadidi, M. Fabrication of Chitosan Nanoparticles Incorporated with Pistacia atlantica subsp. Kurdica Hulls’ Essential Oil as a Potential Antifungal Preservative Against Strawberry Grey Mould. Int. J. Food Sci. Technol. 2021, 56, 4215–4223. [Google Scholar] [CrossRef]
- Hernández-Carranza, P.; Ávila-Sosa, R.; Guerrero-Beltrán, J.A.; Navarro-Cruz, A.R.; Corona-Jiménez, E.; Ochoa-Velasco, C.E. Optimization of Antioxidant Compounds Extraction from Fruit By-Products: Apple Pomace, Orange and Banana Peel. J. Food Process. Preserv. 2016, 40, 103–115. [Google Scholar] [CrossRef]
- Martins, S.; Mussatto, S.I.; Martínez-Avila, G.; Montañez-Saenz, J.; Aguilar, C.N.; Teixeira, J.A. Bioactive Phenolic Compounds: Production and Extraction by Solid-State Fermentation. A Review. Biotechnol. Adv. 2011, 29, 365–373. [Google Scholar] [CrossRef]
- Qi, F.; Zhang, C.; Jiang, S.; Wang, Q.; Kuerban, K.; Luo, M.; Dong, M.; Zhou, X.; Wu, L.; Jiang, B.; et al. S-Ethyl Ethanethiosulfinate, a Derivative of Allicin, Induces Metacaspase-Dependent Apoptosis through ROS Generation in Penicillium Chrysogenum. Biosci. Rep. 2019, 39, BSR20190167. [Google Scholar] [CrossRef] [PubMed]
- Hayat, S.; Cheng, Z.; Ahmad, H.; Ali, M.; Chen, X.; Wang, M. Garlic, from Remedy to Stimulant: Evaluation of Antifungal Potential Reveals Diversity in Phytoalexin Allicin Content among Garlic Cultivars; Allicin Containing Aqueous Garlic Extracts Trigger Antioxidants in Cucumber. Front. Plant Sci. 2016, 7, 1235. [Google Scholar] [CrossRef] [PubMed]
- Leontiev, R.; Hohaus, N.; Jacob, C.; Gruhlke, M.C.H.; Slusarenko, A.J. A Comparison of the Antibacterial and Antifungal Activities of Thiosulfinate Analogues of Allicin. Sci. Rep. 2018, 8, 6763. [Google Scholar] [CrossRef] [PubMed]
- Czepukojc, B.; Leroch, M.; Salm, F.; Viswanathan, U.M.; Burkholz, T.; Hahn, M.; Jacob, C. Antifungal Activity of Tetrasulfanes against Botrytis cinerea. Nat. Prod. Commun. 2013, 8, 1599–1603. [Google Scholar] [CrossRef] [PubMed]
- Kallel, F.; Driss, D.; Chaari, F.; Belghith, L.; Bouaziz, F.; Ghorbel, R.; Chaabouni, S.E. Garlic (Allium sativum L.) Husk Waste as a Potential Source of Phenolic Compounds: Influence of Extracting Solvents on Its Antimicrobial and Antioxidant Properties. Ind. Crops Prod. 2014, 62, 34–41. [Google Scholar] [CrossRef]
- Ourouadi, S.; Hasib, A.; Moumene, H.; El Khiraoui, A.; Ouatmane, A.; Boulli, A.A. Bioactive Constituents and Antioxidant Activity of Moroccan garlic (Allium sativum L.). J. Nat. Sci. Res. 2016, 6, 38–43. [Google Scholar]
- Chhouk, K.; Uemori, C.; Wahyudiono; Kanda, H.; Goto, M. Extraction of Phenolic Compounds and Antioxidant Activity from Garlic Husk Using Carbon Dioxide Expanded Ethanol. Chem. Eng. Process. Process Intensif. 2017, 117, 113–119. [Google Scholar] [CrossRef]
- Chen, S.; Shen, X.; Cheng, S.; Li, P.; Du, J.; Chang, Y.; Meng, H. Evaluation of Garlic Cultivars for Polyphenolic content and Antioxidant Properties. PLoS ONE 2013, 8, e79730. [Google Scholar] [CrossRef]
- Lu, X.; Ross, C.; Powers, J.R.; Aston, D.E.; Rasco, B.A. Determination of Total Phenolic Content and Antioxidant Activity of Garlic (Allium sativum) and Elephant Garlic (Allium ampeloprasum) by Attenuated Total Reflectance-Fourier Transformed Infrared Spectroscopy. J. Agric. Food Chem. 2011, 59, 5215–5221. [Google Scholar] [CrossRef]
- Ilić, D.P.; Stojanović, S.; Najman, S.; Nikolic, V.D.; Stanojević, L.P.; Taćić, A.; Nikolić, L.B. Biological Evaluation of Synthesized Allicin and Its Transformation Products Obtained by Microwaves in Methanol: Antioxidant Activity and Effect on Cell Growth. Biotechnol. Biotechnol. Equip. 2015, 29, 189–194. [Google Scholar] [CrossRef]
- Ribeiro, L.F.; Bedendo, I.P. Efeito Inibitório de Extratos Vegetais Sobre Colletotrichum Gloeosporioides—Agente Causal Da Podridão de Frutos de Mamoeiro. Sci. Agric. 1999, 56, 1267–1271. [Google Scholar] [CrossRef]
- Chege, E.W.; Kimaru, S.K. Effects of Tithonia Diversifolia and Allium Sativum Extracts on Colletotrichum Gloeosporioides, the Causal Agent of Anthracnose in Avocado. All Life 2021, 14, 209–214. [Google Scholar] [CrossRef]
- Daniel, C.K.; Lennox, C.L.; Vries, F.A. In Vivo Application of Garlic Extracts in Combination with Clove Oil to Prevent Postharvest Decay Caused by Botrytis cinerea, Penicillium Expansum and Neofabraea Alba on Apples. Postharvest Biol. Technol. 2015, 99, 88–92. [Google Scholar] [CrossRef]
- Daniel, C.K.; Lennox, C.L.; Vries, F.A. In-Vitro Effects of Garlic Extracts on Pathogenic Fungi Botrytis cinerea, Penicillium Expansum and Neofabraea Alba. S. Afr. J. Sci. 2015, 111, 1–8. [Google Scholar] [CrossRef]
- Nur Fatimma, A. Efficacy of Allium sativum Extract as Post-Harvest Treatment of Fruit Rot of Mango. Plant Pathol. Quar. 2018, 8, 144–152. [Google Scholar] [CrossRef]

| Factor | Level | |
|---|---|---|
| Solvent | Ethanol | Methanol |
| Solvent concentration (%) | 60 | 80 |
| Temperature (°C) | 25 | 50 |
| Time (h) | 1 | 18 |
| Yield (%) | C. gloeosporioides (%) | B. cinerea (%) | ||||
|---|---|---|---|---|---|---|
| Treatment | Ethanol | Methanol | Ethanol | Methanol | Ethanol | Methanol |
| Control | 5.24 ± 1.90 a,y | 4.84 ± 0.35 a,x | 65.90 ± 0.28 b,x | 70.49 ± 0.82 a,x | 63.09 ± 4.28 a,x | 63.91 ± 4.23 a,x |
| Fermented | 11.10 ± 1.05 a,x | 7.88 ± 0.68 b,x | 31.53 ± 2.54 a,y | 36.03 ± 1.04 a,y | 11.61 ± 1.17 b,z | 36.28 ± 0.31 a,y |
| Steam cooked | 9.68 ± 2.76 a,xy | 8.16 ± 3.18 a,x | 67.71 ± 0.79 b,x | 72.33 ± 1.12 a,x | 40.60 ± 5.40 a,y | 41.00 ± 6.60 a,y |
| Total Flavonoids (mg Quercetin/g) | Total Phenolic Compounds (mg GAE/g) | Antioxidant Capacity (µmol Trolox/g) | ||||
|---|---|---|---|---|---|---|
| Treatment | Ethanol | Methanol | Ethanol | Methanol | Ethanol | Methanol |
| Control | 9.25 ± 0.18 b,z | 10.25 ± 0.11 a,z | 28.52 ± 0.19 b,z | 32.47 ± 0.38 a,z | 86.34 ± 0.84 b,z | 96.16 ± 0.42 a,z |
| Fermented | 12.39 ± 0.18 b,y | 14.03 ± 0.30 a,y | 36.24 ± 0.46 b,y | 40.37 ± 0.79 a,y | 101.36 ± 0.37 b,y | 119.48 ± 0.50 a,y |
| Steam cooked | 16.44 ± 0.11 b,x | 17.90 ± 0.13 a,x | 38.61 ± 0.28 b,x | 60.06 ± 0.18 a,x | 121.59 ± 1.54 b,x | 149.75 ± 1.69 a,x |
| Run | Solvent | Concentration (%) | Temperature (°C) | Time (h) | Yield | C. gloeosporioides | B. cinerea |
|---|---|---|---|---|---|---|---|
| 1 | M | 60 | 25 | 1 | 9.39 ± 0.93 ab | 65.22 ± 0.84 c | 36.05 ± 2.34 d |
| 2 | E | 60 | 25 | 1 | 7.06 ± 0.77 ab | 72.10 ± 0.72 a | 55.73 ± 0.38 ab |
| 3 | M | 80 | 25 | 1 | 6.25 ± 1.44 ab | 53.81 ± 0.80 e | 36.22 ± 1.60 d |
| 4 | E | 80 | 25 | 1 | 5.75 ± 1.63 b | 69.55 ± 0.22 b | 49.04 ± 0.80 abc |
| 5 | M | 60 | 50 | 1 | 11.34 ± 1.06 a | 66.67 ± 3.58 bc | 38.52 ± 2.87 cd |
| 6 | E | 60 | 50 | 1 | 6.08 ± 0.57 ab | 74.49 ± 1.03 ab | 54.23 ± 2.97 ab |
| 7 | M | 80 | 50 | 1 | 6.87 ± 1.19 ab | 70.13 ± 0.88 b | 43.87 ± 5.35 bcd |
| 8 | E | 80 | 50 | 1 | 7.63 ± 2.17 ab | 62.93 ± 0.27 cd | 40.50 ± 3.84 cd |
| 9 | M | 60 | 25 | 18 | 7.30 ± 0.39 ab | 75.76 ± 1.12 a | 57.57 ± 5.36 a |
| 10 | E | 60 | 25 | 18 | 4.96 ± 0.72 b | 74.06 ± 3.10 ab | 54.62 ± 0.78 a |
| 11 | M | 80 | 25 | 18 | 7.43 ± 2.48 ab | 69.40 ± 3.24 b | 39.92 ± 2.32 cd |
| 12 | E | 80 | 25 | 18 | 9.76 ± 2.02 ab | 71.98 ± 0.76 ab | 38.34 ± 1.08 cd |
| 13 | M | 60 | 50 | 18 | 8.16 ± 3.18 ab | 72.33 ± 1.12 ab | 41.00 ± 6.60 cd |
| 14 | E | 60 | 50 | 18 | 9.68 ± 2.76 ab | 67.71 ± 0.79 bc | 40.60 ± 5.40 cd |
| 15 | M | 80 | 50 | 18 | 7.07 ± 2.33 ab | 67.32 ± 2.78 bc | 53.05 ± 1.35 ab |
| 16 | E | 80 | 50 | 18 | 8.00 ± 2.04 ab | 59.67 ± 1.34 d | 40.97 ± 4.01 cd |
Disclaimer/Publisher’s Note: The statements, opinions and data contained in all publications are solely those of the individual author(s) and contributor(s) and not of MDPI and/or the editor(s). MDPI and/or the editor(s) disclaim responsibility for any injury to people or property resulting from any ideas, methods, instructions or products referred to in the content. |
© 2023 by the authors. Licensee MDPI, Basel, Switzerland. This article is an open access article distributed under the terms and conditions of the Creative Commons Attribution (CC BY) license (https://creativecommons.org/licenses/by/4.0/).
Share and Cite
Carreón-Delgado, D.F.; Hernández-Montesinos, I.Y.; Rivera-Hernández, K.N.; del Sugeyrol Villa-Ramírez, M.; Ochoa-Velasco, C.E.; Ramírez-López, C. Evaluation of Pretreatments and Extraction Conditions on the Antifungal and Antioxidant Effects of Garlic (Allium sativum) Peel Extracts. Plants 2023, 12, 217. https://doi.org/10.3390/plants12010217
Carreón-Delgado DF, Hernández-Montesinos IY, Rivera-Hernández KN, del Sugeyrol Villa-Ramírez M, Ochoa-Velasco CE, Ramírez-López C. Evaluation of Pretreatments and Extraction Conditions on the Antifungal and Antioxidant Effects of Garlic (Allium sativum) Peel Extracts. Plants. 2023; 12(1):217. https://doi.org/10.3390/plants12010217
Chicago/Turabian StyleCarreón-Delgado, David Fernando, Itzel Yoali Hernández-Montesinos, Karla Nallely Rivera-Hernández, María del Sugeyrol Villa-Ramírez, Carlos Enrique Ochoa-Velasco, and Carolina Ramírez-López. 2023. "Evaluation of Pretreatments and Extraction Conditions on the Antifungal and Antioxidant Effects of Garlic (Allium sativum) Peel Extracts" Plants 12, no. 1: 217. https://doi.org/10.3390/plants12010217
APA StyleCarreón-Delgado, D. F., Hernández-Montesinos, I. Y., Rivera-Hernández, K. N., del Sugeyrol Villa-Ramírez, M., Ochoa-Velasco, C. E., & Ramírez-López, C. (2023). Evaluation of Pretreatments and Extraction Conditions on the Antifungal and Antioxidant Effects of Garlic (Allium sativum) Peel Extracts. Plants, 12(1), 217. https://doi.org/10.3390/plants12010217

